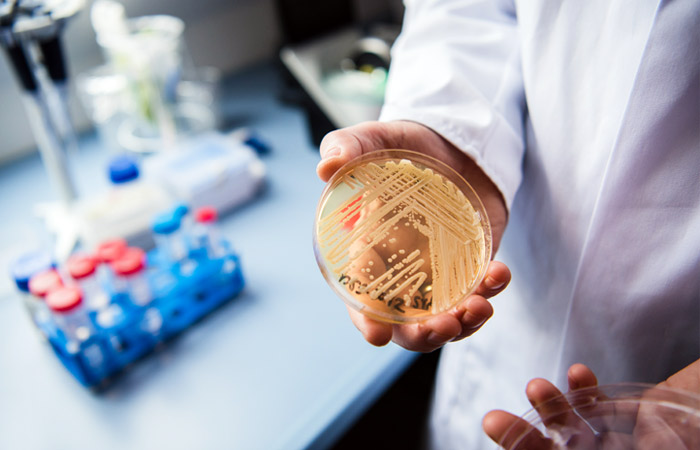

Счетная палата сочла госсподдержку молодых ученых неэффективной
Термин "молодой ученый" - слишком размытый, поэтому сложно определить даже достоверный объем финансирования
Москва. 5 марта. INTERFAX.RU - Меры господдержки молодых ученых несистемны и малоэффективны, из-за отсутствия системного подхода к данному вопросу нет понимания, сколько в них вкладывается денег и каков эффект от этих инвестиций, к таким выводам Счетная палата пришла по итогам анализа реализации мер государственной поддержки молодых российских ученых в 2016-2018 годы.
По данным ведомства, на 1 января 2018 года численность исследователей в возрасте до 39 лет составляла 157 тыс. 805 человек или почти 44% от общего числа ученых РФ. Однако в ходе анализа СП установила, что, по данным Росстата, в наукоградах трудится почти 47 тыс. ученых, а по данным Минобрнауки, - только 28 тыс., таким образом, расхождение составило 40%.
По словам аудитора Светланы Орловой, разница в подсчетах вызвана размытостью термина "молодой ученый": по разным документам под него подходят, как аспиранты и кандидаты наук в возрасте до 35 лет, доктора наук до 40 лет, а в некоторых случаях - до 45 лет, так и не имеющие степени исследователи до 33 лет.
В связи с этим СП предлагает закрепить понятие "молодой ученый", а Минобрнауки совместно с Росстатом - доработать формы отчетности. Замглавы министерства Георгий Трубников сообщил на коллегии ведомства, что это планируется сделать "в рамках новой редакции закона о науке", а также вместе с Росстатом ведется работа по приведению в порядок статистического учета молодых ученых.
Единый статистический подход позволит качественно проводить финансово-кадровую политику, достоверно определить общий объем средств, которые направляются на поддержку молодых ученых, подчеркнули в СП РФ.
"В ходе анализа установить достоверный объем финансирования не удалось. Минобрнауки не обладает этими данными", - отмечается в сообщении.
По самым скромным подсчетам, в 2018 году на поддержку молодых ученых было направлено 12,7 млрд руб. При этом за счет региональных бюджетов поддержку получает ежегодно не более 4% молодых ученых. "Между тем, отсутствие достоверных данных не позволяет объективно оценить достаточность и эффективность реализуемых мер для решения стратегических задач государства", - заявила Орлова.
Также она отметила, что положения стратегических документов в ряде случаев не реализованы. В частности, отмечается "провал" ученых среднего возраста - их менее 22%, недостаточно оперативно решается задача планирования карьеры молодого ученого; до сих пор не готова программа строительства современной жилищной и социальной инфраструктуры для ученых, которая должна была быть утверждена до 31 августа 2018 года.
Замминистра признал, что "очень малый процент исследователей занимают руководящие должности". По его словам, в рамках нацпроекта запланировано несколько мероприятий - порядка 7 тыс. новых лабораторий-проектов, которые должны возглавить ученые не старше 39 лет; готовится программа инновационного жилья.
Кроме того, по мнению Счетной палаты, грантовое финансирование не нацелено на конечный результат, а именно - на экономический эффект.
Коллегия приняла решение направить информационное письмо в правительство РФ и в Минобрнауки, отчет - в палаты Федерального собрания.














